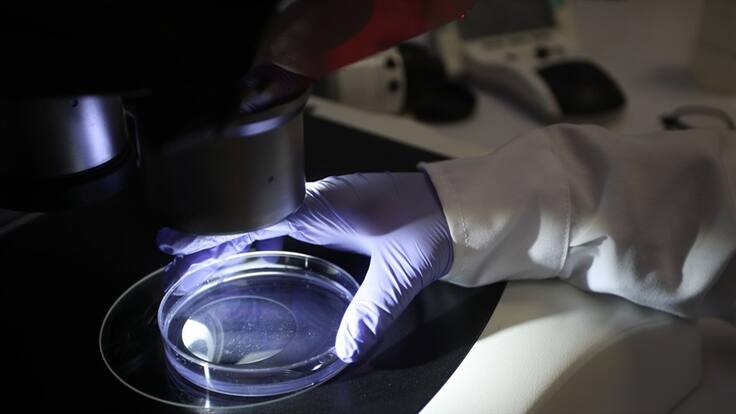
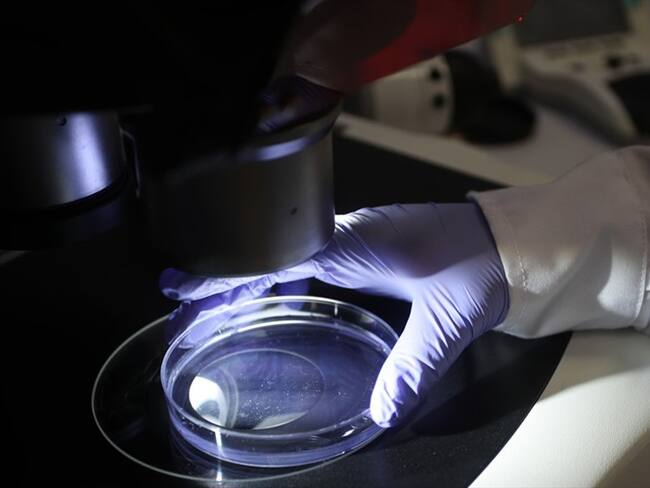
Nuevo tratamiento contra cáncer de cuello uterino, entre las patentes de la Univalle

Nuevo tratamiento contra cáncer de cuello uterino, entre las patentes de la Univalle
La institución es uno de los referentes de Colombia en cuanto a las patentes.
Nuevo tratamiento contra cáncer de cuello uterino, entre las patentes de la Univalle
12:44
Compartir
El código iframe se ha copiado en el portapapeles
Tratamientos científicos. Foto: Referencia Getty
Edgar Varela Barrios, rector de la Universidad del Valle, pasó por los micrófonos de La Hora Del Regreso para hablar sobre las ocho patentes que han recibido durante el 2020.
“Hemos estado los últimos diez años recibiendo más o menos entre ocho y quince patentes año a año. Lo innovativo de las patentes es el trabajo multidisciplinario porque son hechas con profesores de distintas áreas”, indicó.
“Dos de ellas: la primera es un licenciamiento en México de nanocompuestos que incorporan óxido de titanio para el de cáncer de cuello uterino no quirúrgico; la segunda es un dispositivo de fijación externa para estabilizar las fracturas de los huesos”, añadió.
Por otro lado, Varela explicó por qué, para algunas de sus patentes, buscan en países como México y Brasil.
“La mayoría de nuestras patentes se hicieron en Estados Unidos y las de Brasil y México se han dado por trabajo cooperativo en investigación”, afirmó.



